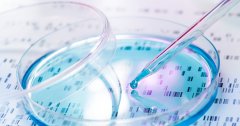

在四川地区,华西医院被广大患者誉为试管领域的佼佼者。华西医院作为一所综合性三甲医院,在不孕不育领域积累了丰富的经验和技术,并取得了显着的成果。该医院采用国际先进的试管技术,配备了一流的设备和专家团队,为广大患者提供高质量的服务。

四川做得成功的试管医院详细介绍
华西医院拥有一支由多位知名专家组成的试管团队。这些专家在不孕不育领域具有丰富的临床经验和卓越的手术技术,能够根据患者个体情况制定个性化的治疗方案。他们精湛的操作技术以及对患者全程关怀和指导,使得试管手术成功率大幅提升。
华西医院配备了一流设备和先进技术。该医院引进了国际先进的辅助生殖技术,包括体外受精、胚胎培养和冷冻保存等。这些技术的运用大大提高了试管的成功率。同时华西医院还拥有一流的实验室设备和高效的质控体系,确保每个环节都能够达到最高标准。
华西医院注重患者个性化治疗。针对不同患者的具体情况和需求,医院制定了个性化的治疗方案。在试管手术前进行全面评估,包括患者年龄、卵巢功能、子宫内膜厚度等因素,并根据评估结果进行相应调整。这种个性化治疗策略能够最大程度地提高试管成功率,并降低不孕不育患者的心理负担。
华西医院试管的风险和并发症
在进行试管手术期间,华西医院为患者提供全程关怀服务。在手术前医生会对患者进行详细的介绍和解释,让患者了解整个手术过程以及可能的风险和并发症。其次在手术过程中医生会密切关注患者的身体状况,确保手术顺利进行,并及时采取相应措施处理意外情况。最后,在手术后医生会对患者进行复诊和随访,了解患者的康复情况,并根据需要进行进一步治疗。
华西医院还为试管患者提供心理支持。不孕不育本身就是一种心理负担较重的疾病,而试管手术更是涉及到家庭幸福和个人希望的重大事件。因此华西医院设有专门的心理咨询团队,为患者提供心理辅导和支持,帮助他们减轻焦虑和压力,并积极面对治疗。
华西医院试管的优势与口碑
除了以上提到的优势外,华西医院在试管领域还有其他突出之处。该医院拥有完善的后期服务体系,包括孕前检查、孕期管理和产后护理等。这些完善的服务能够确保试管患者在整个生育过程中得到全方位的关爱和支持。
华西医院注重科研与教学。作为一所综合性医院,该院不仅致力于临床工作,还积极开展科研项目和教学活动。这种注重科研与教学的态度使得该医院始终站在试管领域的前沿,并能及时将最新的科研成果应用到临床实践中,提升治疗效果。
华西医院以其良好的声誉和专业形象赢得了广大患者的信任。多年来,该院通过优质的服务和良好的治疗效果树立了良好口碑,在四川地区享有盛誉。许多患者选择华西医院进行试管手术,正是因为他们对该医院技术水平和服务质量的高度认可。
四川华西医院在试管领域取得了显着成绩,其成功率高、个性化治疗和全程关怀服务深受患者青睐。无论是专业的团队、先进的设备,还是完善的服务体系,都使得华西医院成为四川地区试管的首选医院。